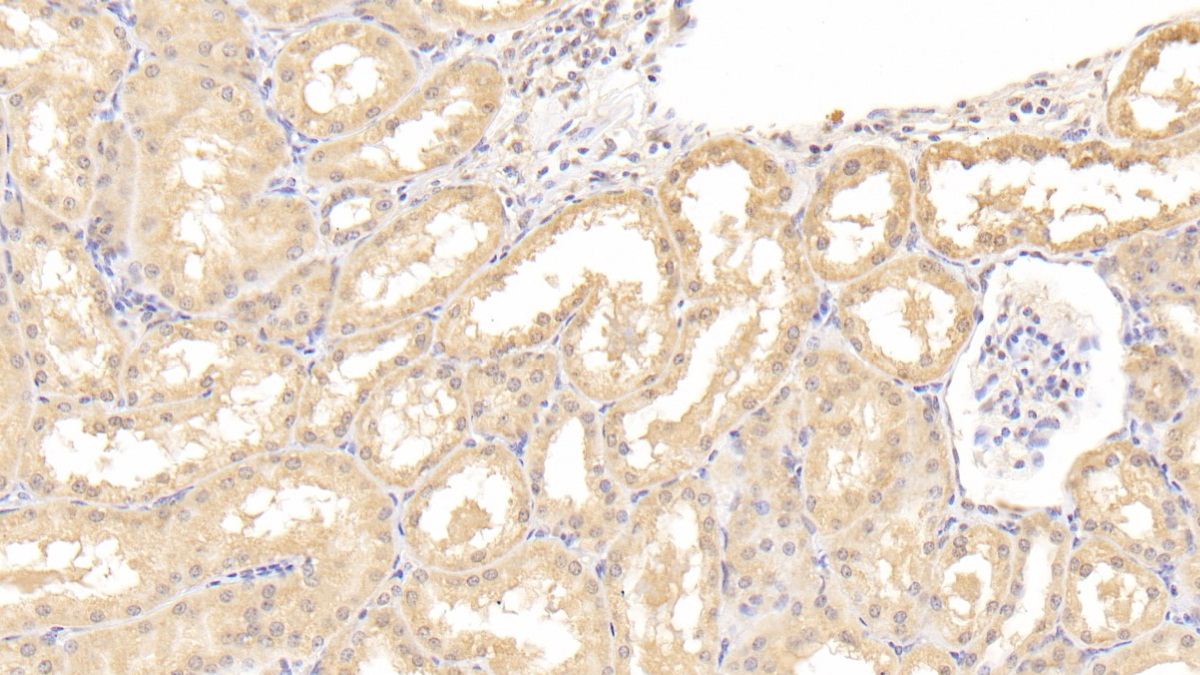
https://d1vffmuvmgkypt.cloudfront.net/image/ridacom_ltd/cloud_clone_corp/PRODUCT_SOURCE__CLOUD_CLONE__SUPPLIER__RIDACOM__ID__PAA081Hu01__1

Antigen
HP40
Reactivity
Human
(4)
Rat
(3)
Mouse
(2)
Research area
Apoptosis
(3)
Cytokine
(3)
Hematology
(3)
Infection immunity
(3)
Clonality
Monoclonal
(1)
Polyclonal
(1)
Application
Enzyme-linked immunosorbent assay for Antigen Detection
(5)
Western Blotting
(3)
Immunocytochemistry
(2)
Immunohistochemistry
(2)
Immunoprecipitation
(2)
Chemiluminescent immunoassay for antigen detection
(1)
Positive Control
(1)
SDS-PAGE
(1)
Host
Mouse
(1)
Rabbit
(1)
Category
ELISA Kits
(6)
Antibodies
(2)
Cell biology
(1)
Immunochemicals
(1)
Protein Biochemistry
(1)
| 48T | $638.00 | |
| 96T | $912.00 | |
| 96T*5 | $4,104.00 |
| 96T*10 | $7,752.00 | |
| 96T*100 | $63,840.00 |
| 48T | $575.00 | |
| 96T | $821.00 | |
| 96T*5 | $3,695.00 |
| 96T*10 | $6,979.00 | |
| 96T*100 | $57,470.00 |
| 48T | $545.00 | |
| 96T | $778.00 | |
| 96T*5 | $3,501.00 |
| 96T*10 | $6,613.00 | |
| 96T*100 | $54,460.00 |
| 48T | $479.00 | |
| 96T | $684.00 | |
| 96T*5 | $3,078.00 |
| 96T*10 | $5,814.00 | |
| 96T*100 | $47,880.00 |
| 48T | $454.00 | |
| 96T | $648.00 | |
| 96T*5 | $2,916.00 |
| 96T*10 | $5,508.00 | |
| 96T*100 | $45,360.00 |
| 48T | $441.00 | |
| 96T | $630.00 | |
| 96T*5 | $2,835.00 |
| 96T*10 | $5,355.00 | |
| 96T*100 | $44,100.00 |

Antigen:
Interleukin 9
Synonyms: HP40; P40; TCGFIII; TCGF3; T Cell Growth Factor III; P40 T-Cell And Mast Cell Growth Factor; P40 Cytokine; Homolog Of Mouse T Cell And Mast Cell Growth Factor 40
Reactivity:Human
Application:Positive Control; SDS-PAGE; Western Blotting
Research area:Cytokine; Apoptosis; Infection immunity; Hematology
Preparation method:Escherichia coli
| 10µg | $187.00 | |
| 50µg | $468.00 | |
| 200µg | $936.00 |
| 1mg | $2,808.00 | |
| 5mg | $7,020.00 |

Antigen:
Interleukin 9
Synonyms: HP40; P40; TCGFIII; TCGF3; T Cell Growth Factor III; P40 T-Cell And Mast Cell Growth Factor; P40 Cytokine; Homolog Of Mouse T Cell And Mast Cell Growth Factor 40
Host:Mouse
Reactivity:Human
Application:Western Blotting; Immunohistochemistry; Immunocytochemistry; Immunoprecipitation
Isotype:IgG1
Clonality:Monoclonal
Research area:Cytokine; Apoptosis; Infection immunity; Hematology
| 20µl | $101.00 | |
| 100µl | $235.00 | |
| 200µl | $336.00 |
| 1ml | $840.00 | |
| 10ml | $3,360.00 |
Antigen:
Interleukin 9
Synonyms: HP40; P40; TCGFIII; TCGF3; T Cell Growth Factor III; P40 T-Cell And Mast Cell Growth Factor; P40 Cytokine; Homolog Of Mouse T Cell And Mast Cell Growth Factor 40
Host:Rabbit
Reactivity:Human
Application:Western Blotting; Immunohistochemistry; Immunocytochemistry; Immunoprecipitation
Clonality:Polyclonal
Research area:Cytokine; Apoptosis; Infection immunity; Hematology
| 20µl | $95.00 | |
| 100µl | $221.00 | |
| 200µl | $316.00 |
| 1ml | $790.00 | |
| 10ml | $3,160.00 |




-SCA081Ra-000001.png)



-MEA081Ra-000001.png)





-SEA081Ra-000001.png)



-E90081Mu-000001.png)



-SEA081Hu-000001.png)




-MAA081Hu22-000001.png)



-PAA081Hu01-000001.png)